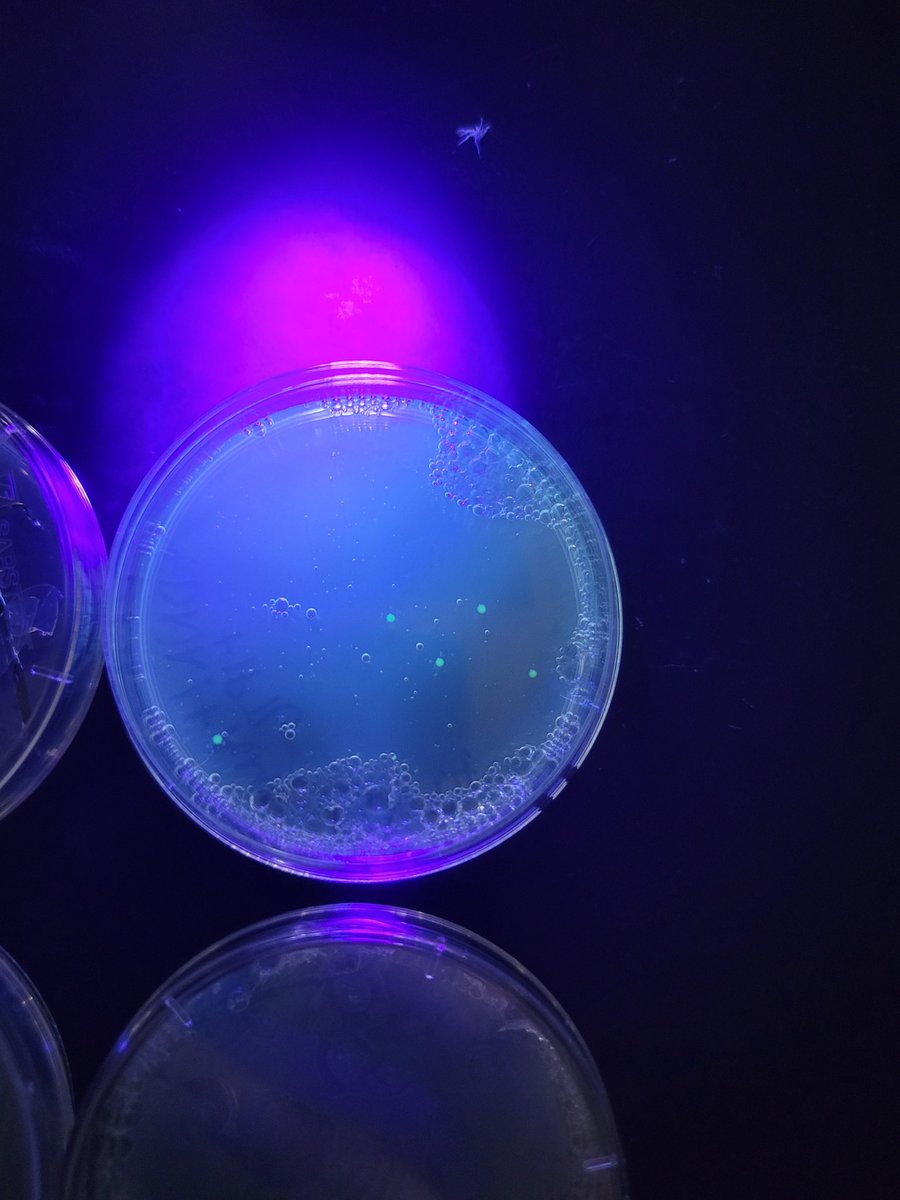
HawleyScience's tweet image. Thank you @edvotek for the #gifted  lab kit in return for an honest review. My PLTW Biomedical Innovations students enjoyed learning about gene editing in the context of medical research. We had one success out of 10 tries. Pretty good for our first time editing genes!

Sarah Hawley
@HawleyScience
Teaching, science-ing, knitting, crafting, hiking, biking, mommying, wife-ing...I do it all!
You might like
I have some amazingly talented friends. @gertrudkrumpf makes the most darling animal sculptures and her mugs are the perfect size!
GFP Gene Editing with Juniors and Seniors! blog.edvotek.com/2022/09/27/gfp…
blog.edvotek.com
GFP Gene Editing with Juniors and Seniors!
EDVO-Kit #223-AP08 Transformation of E. coli with Green Fluorescent Protein (GFP) This is a guest post from Sarah Hawley, a biomedical science teacher at Richmond High School, IN. Last year I was a…
We investigated a crime scene #RHSBMS @HawleyScience @LearnatRHS @PLTWorg

Thank you @edvotek for the #gifted lab kit in return for an honest review. My PLTW Biomedical Innovations students enjoyed learning about gene editing in the context of medical research. We had one success out of 10 tries. Pretty good for our first time editing genes!
Congratulations Jackson F. 2nd place in Pathophysiology at HOSA SLC #wercareers #RHSBMS #LearnatRHS

Congratulations Maria A. finalist in Pathophysiology at HOSA SLC #wercareers #RHSBMS #LearnatRHS

Congratulations Manahil R, 3rd place in Nutrition at HOSA SLC. #wercareers #RHSBMS #LearnatRHS

Congratulations to Kyleigh M. Medical Law and Ethics finalist at HOSA SLC! #wercareers #RHSBMS #LearnatRHS

@RHSBMS Has been enjoying our time at the HOSA State Leadership Conference. #LearnatRHS #wercareers

We have demonstrated that power and potential of Wolbachia as a game-changing public health tool. We have so far reached 8 million people across 11 countries. We must ensure that this approach is affordable and accessible to billions of people worldwide. gatesphilanthropypartners.org/perspectives/2…
Today I stand up for educator and student rights. Because sometimes teaching is more than being in the classroom it is leading by example. @LearnatRHS @RCSLearn

Thank you @aamyxforPBS for being my Anna today! You played an excellent decedent. #RHSBMS @learnatRHS @PLTWorg

I teach because I love to learn new things. I teach science because it is fun. @wearrrichmond
All set up for Principles of Bimoed students to try their hand at phlebotomy. #PLTW #RHSBMS #LearnatRHS #rcslearn

United States Trends
- 1. #UFC324 N/A
- 2. #SNME N/A
- 3. #Skyscrapperlive N/A
- 4. Alex Pretti N/A
- 5. Silva N/A
- 6. Alex N/A
- 7. Minnesota N/A
- 8. Minneapolis N/A
- 9. Sami N/A
- 10. Taipei 101 N/A
- 11. Kyle Rittenhouse N/A
- 12. Moro N/A
- 13. Gautier N/A
- 14. #DragonBallSuper N/A
- 15. Nakamura N/A
- 16. Arnold Allen N/A
- 17. #AEWCollision N/A
- 18. Ayton N/A
- 19. Noem N/A
- 20. Brandon Williams N/A
Something went wrong.
Something went wrong.














































































































